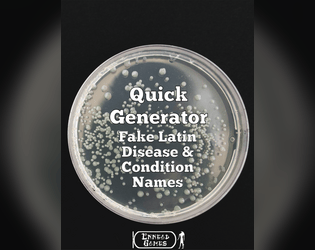

Latesttagged Generator (228 results)
Explore books tagged Generator on itch.io · Upload your books to itch.io to have them show up here.
New itch.io is now on YouTube!
Subscribe for game recommendations, clips, and more
View Channel
Ideas and concepts for sci-fi/modern character or NPC encounters
Armour and clothing ideas and concepts with a touch of the divine
Tables and ideas for making an outline about a guild of assassins!
Names , concepts and ideas for creatures variants based on the periodic table
Make names for various sport teams from around the world
Names for secret groups, “secret” groups and other similar organisations
37,500 possible names for hospitals, wards, facility and other medical and healing related places.
Quick descriptions for magical potions, teas, beers and more!
All in the Creature Concepts series, combined to allow for even more options!
A short example of a legendary story generated with Modular Myths
Educational and informative non-fictional titles for the fantasy genre settings
Concepts, descriptions and names for bugs, insects and other creepy crawlies
Concepts, descriptions and names for creatures found in a desert environment
20,000 possible titles and concepts for criminals.
4,000,000 names for alliances and empires!
Concepts, quick descriptions and ideas for familiars!
Concepts and ideas for rooms and areas on a station or colony.
What awaits in the watery depths?
A place of work and somewhere to call home for those who explore the stars
Whats the name of the settlement or starbase found in the void?
Names and concepts for beautiful yet often deadly places…
Titles/Names/Topics for non-fiction books in fantasy worlds
It’s party time…what could go wrong?!
Get together your crew for a heist!
When you want to spend some time down by the river…
Loading more games...